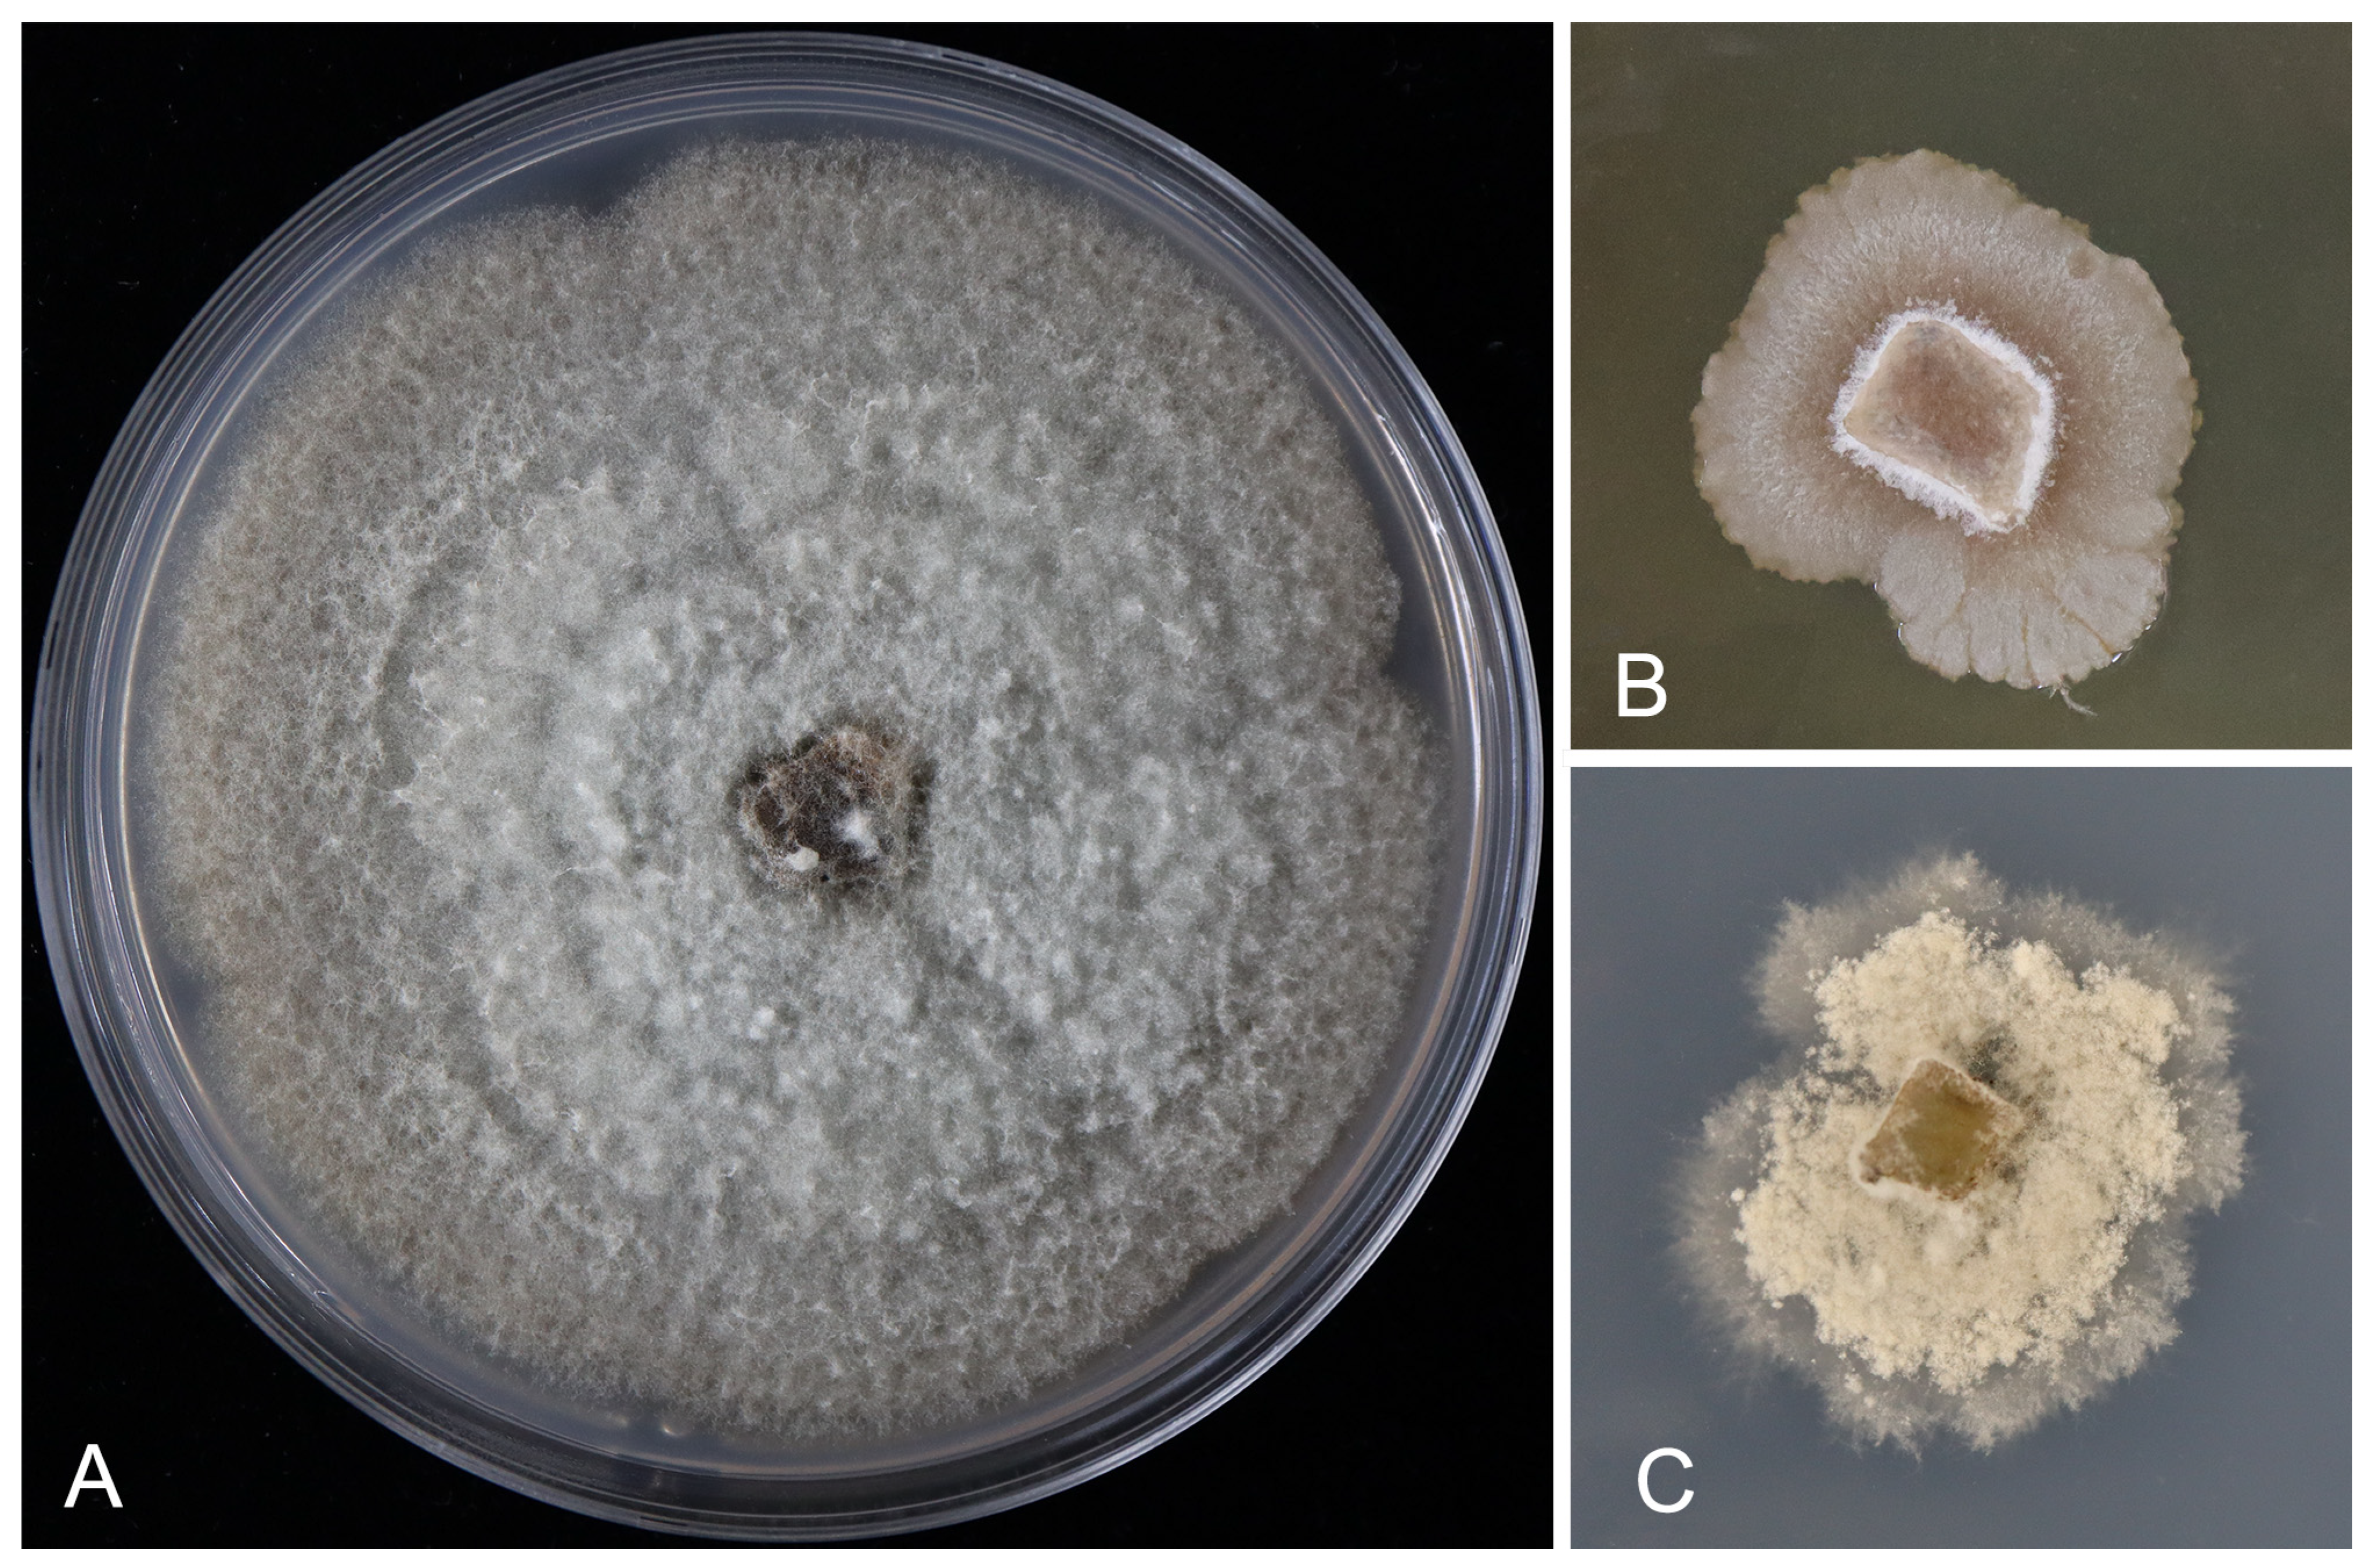

Seimatosporium chinense, a Novel Pestalotioid Fungus Associated with Yellow Rose Branch Canker Disease
Abstract
1. Introduction
2. Materials and Methods
2.1. Disease Investigation, Sample Collection and Fungal Isolation
2.2. Morphological Observation
2.3. Molecular Studies
3. Results
3.1. Disease Symptoms and Incidence
3.2. Phylogeny
3.3. Description of the New Species
4. Discussion
Author Contributions
Funding
Institutional Review Board Statement
Informed Consent Statement
Data Availability Statement
Conflicts of Interest
References
- Gao, C.; Wu, C.; Zhang, Q.; Wu, M.; Chen, R.; Zhao, Y.; Li, Z. Sequence and phylogenetic analysis of the chloroplast genome for Rosa xanthina. Mitochondrial DNA Part B 2020, 5, 2922–2923. [Google Scholar] [CrossRef] [PubMed]
- Zhuang, D.; Ma, C.; Xue, L.; Li, Z.; Wang, C.; Lei, J.; Yuan, X. Transcriptome and de novo analysis of Rosa xanthina f. spontanea in response to cold stress. BMC Plant Biol. 2001, 21, 1–11. [Google Scholar]
- Sun, Y.; Yang, Y.; Zhou, M.; Luo, L.; Pan, H.; Zhang, Q.; Yu, C. Widely targeted metabolic profiling reveals differences in polyphenolic metabolites during Rosa xanthina f. spontanea fruit development and ripening. Metabolites 2022, 12, 438. [Google Scholar] [PubMed]
- Huang, C.H.; Vallad, G.E.; Adkison, H.; Summers, C.; Margenthaler, E.; Schneider, C.; Norman, D.J. A novel Xanthomonas sp. causes bacterial spot of rose (Rosa spp.). Plant Dis. 2013, 97, 1301–1307. [Google Scholar] [CrossRef] [PubMed][Green Version]
- Félix-Gastélum, R.; Herrera-Rodríguez, G.; Martínez-Valenzuela, C.; Maldonado-Mendoza, I.E.; Quiroz-Figueroa, F.R.; Brito-Vega, H.; Espinosa-Matías, S. First report of powdery mildew (Podosphaera pannosa) of roses in Sinaloa, Mexico. Plant Dis. 2014, 98, 1442. [Google Scholar] [CrossRef]
- Caio, P.; Bruno, F.; Carlos, A.P.; Robert, B. Diaporthe rosiphthora sp. nov.: Yet another rose dieback fungus. Crop Prot. 2021, 139, 105365. [Google Scholar] [CrossRef]
- Jiang, N.; Bonthond, G.; Fan, X.L.; Tian, C.M. Neopestalotiopsis rosicola sp. nov. causing stem canker of Rosa chinensis in China. Mycotaxon 2018, 133, 271–283. [Google Scholar] [CrossRef]
- Liu, F.; Bonthond, G.; Groenewald, J.Z.; Cai, L.; Crous, P.W. Sporocadaceae, a family of coelomycetous fungi with appendage-bearing conidia. Stud. Mycol. 2019, 92, 287–415. [Google Scholar] [CrossRef]
- Peng, C.; Crous, P.W.; Jiang, N.; Fan, X.L.; Liang, Y.M.; Tian, C.M. Diversity of Sporocadaceae (pestalotioid fungi) from Rosa in China. Persoonia 2022, 49, 201–260. [Google Scholar] [CrossRef]
- Jiang, N.; Voglmayr, H.; Xue, H.; Piao, C.G.; Li, Y. Diversity of Monochaetia species from fagaceous leaf spots in China and pathogenicity for Chinese chestnut. Microbiol. Spectr. 2023, 11, e00042-23. [Google Scholar] [CrossRef]
- Zhang, Z.; Liu, R.; Liu, S.; Mu, T.; Zhang, X.; Xia, J. Morphological and phylogenetic analyses reveal two new species of Sporocadaceae from Hainan, China. MycoKeys 2022, 88, 171. [Google Scholar] [CrossRef] [PubMed]
- Song, J.Y.; Wu, H.X.; Li, J.C.; Ding, W.F.; Gong, C.L.; Zeng, X.Y.; Yang, D.X. Taxonomy and evolution history of two new litter-decomposing Ciliochorella (Amphisphaeriales, Sporocadaceae). MycoKeys 2023, 100, 95. [Google Scholar] [CrossRef] [PubMed]
- Jiang, N.; Voglmayr, H.; Xue, H.; Piao, C.G.; Li, Y. Morphology and phylogeny of Pestalotiopsis (Sporocadaceae, Amphisphaeriales) from Fagaceae leaves in China. Microbiol. Spectr. 2022, 10, e03272-22. [Google Scholar] [CrossRef] [PubMed]
- Yin, C.; Zhang, Z.; Wang, S.; Ma, L.; Zhang, X. Three new species of Pestalotiopsis (Amphisphaeriales, Sporocadaceae) were identified by morphology and multigene phylogeny from Hainan and Yunnan, China. MycoKeys 2024, 107, 51. [Google Scholar] [CrossRef] [PubMed]
- Maharachchikumbura, S.S.; Hyde, K.D.; Groenewald, J.Z.; Xu, J.; Crous, P.W. Pestalotiopsis revisited. Stud. Mycol. 2014, 79, 121–186. [Google Scholar] [CrossRef]
- Jiang, N.; Tian, L.Y.; Xue, H.; Piao, C.G.; Li, Y. Pestalotiopsis sonneratiae sp. nov. from China. Mycotaxon 2023, 137, 725–735. [Google Scholar] [CrossRef]
- Razaghi, P.; Raza, M.; Han, S.L.; Ma, Z.Y.; Cai, L.; Zhao, P.; Liu, F. Sporocadaceae revisited. Stud. Mycol. 2024, 109, 255–272. [Google Scholar] [CrossRef]
- Kanetis, L.I.; Taliadoros, D.; Makris, G.; Christoforou, M. A novel Seimatosporium and other Sporocadaceae species associated with grapevine trunk diseases in Cyprus. Plants 2022, 11, 2733. [Google Scholar] [CrossRef]
- Goonasekara, I.D.; Maharachchikumbura, S.S.; Wijayawardene, N.N.; Phookamsak, R.; Schumacher, R.K.; Bahkali, A.H.; Hyde, K. Seimatosporium quercina sp. nov.(Discosiaceae) on Quercus robur from Germany. Phytotaxa 2016, 255, 240–248. [Google Scholar] [CrossRef]
- Lawrence, D.P.; Travadon, R.; Baumgartner, K. Novel Seimatosporium species from grapevine in northern California and their interactions with fungal pathogens involved in the trunk-disease complex. Plant Dis. 2018, 102, 1081–1092. [Google Scholar] [CrossRef]
- Moghadam, J.N.; Khaledi, E.; Abdollahzadeh, J.; Amini, J. Seimatosporium marivanicum, Sporocadus kurdistanicus, and Xenoseimatosporium kurdistanicum: Three new pestalotioid species associated with grapevine trunk diseases from the Kurdistan Province, Iran. Mycol. Prog. 2022, 21, 427–446. [Google Scholar] [CrossRef]
- Dardani, G.; Mugnai, L.; Bussotti, S.; Gullino, M.L.; Guarnaccia, V. Grapevine dieback caused by Botryosphaeriaceae species, Paraconiothyrium brasiliense, Seimatosporium vitis-viniferae and Truncatella angustata in Piedmont: Characterization and pathogenicity. Phytopathol. Mediterr. 2023, 60, 283–306. [Google Scholar] [CrossRef]
- Doyle, J.J.; Doyle, J.L. Isolation of plant DNA from fresh tissue. Focus 1990, 12, 13–15. [Google Scholar]
- White, T.J.; Bruns, T.; Lee, S.; Taylor, J. Amplification and direct sequencing of fungal ribosomal RNA genes for phylogenetics. PCR Protoc. Guide Methods Appl. 1990, 18, 315–322. [Google Scholar]
- O’Donnell, K.; Cigelnik, E. Two divergent intragenomic rDNA ITS2 types within a monophyletic lineage of the fungus Fusarium are non-orthologous. Mol. Phylogenet. Evol. 1997, 7, 103–116. [Google Scholar] [CrossRef]
- Carbone, I.; Kohn, L.M. A method for designing primer sets for speciation studies in filamentous ascomycetes. Mycologia 1999, 91, 553–556. [Google Scholar] [CrossRef]
- Glass, N.L.; Donaldson, G.C. Development of primer sets designed for use with the PCR to amplify conserved genes from filamentous ascomycetes. Appl. Environ. Microb. 1995, 61, 1323–1330. [Google Scholar] [CrossRef]
- Liu, Y.J.; Whelen, S.; Hall, B.D. Phylogenetic relationships among ascomycetes: Evidence from an RNA polymerse II subunit. Mol. Biol. Evol. 1999, 16, 1799–1808. [Google Scholar] [CrossRef]
- Miller, M.A.; Pfeiffer, W.; Schwartz, T. Creating the CIPRES Science Gateway for Inference of Large Phylogenetic Trees. In Proceedings of the 2010 Gateway Computing Environments Workshop (GCE), New Orleans, LA, USA, 14 November 2010. [Google Scholar]
- Stamatakis, A. RAxML version 8: A tool for phylogenetic analysis and post-analysis of large phylogenies. Bioinformatics 2014, 30, 312–1313. [Google Scholar] [CrossRef]
- Ronquist, F.; Huelsenbeck, J.P. MrBayes 3: Bayesian phylogenetic inference under mixed models. Bioinformatics 2003, 19, 1572–1574. [Google Scholar] [CrossRef]
- Baradaran, G.R.; Aminaee, M.M.; Assari, M.J. Identification of fungal diseases of Rosa damascena in Kerman province of Iran. Arch. Phytopathol. Plant Prot. 2012, 45, 1087–1095. [Google Scholar] [CrossRef]

| Species | Strain | Host | Country | GenBank Accession Number | ||||
|---|---|---|---|---|---|---|---|---|
| ITS | LSU | rpb2 | tef1 | tub2 | ||||
| Distononappendiculata banksiae | CBS 131308 * | Banksia marginata (Proteaceae) | Australia | JQ044422 | AB593705 | NA | NA | MH554670 |
| Seimatosporium botan | NBRC 104200 * | Paeonia suffruticosa (Paeoniaceae) | Japan | AB594799 | AB593731 | NA | NA | LC047770 |
| Seimatosporium centrale | CFCC 55166 * | Rosa chinensis (Rosaceae) | China | OK560629 | OK560399 | ON055447 | OM986918 | OM301641 |
| Seimatosporium centrale | CFCC 55169 | Rosa chinensis (Rosaceae) | China | OK560632 | OK560402 | ON055450 | OM986921 | OM301644 |
| Seimatosporium chinense | CFCC 70988 * | Rosa xanthina (Rosaceae) | China | PQ279535 | PQ279531 | PQ283812 | PQ287323 | PQ287325 |
| Seimatosporium chinense | N001A | Rosa xanthina (Rosaceae) | China | PQ279536 | PQ279532 | PQ283813 | PQ287324 | PQ287326 |
| Seimatosporium cyprium | CBS 149019 * | Vitis vinifera (Vitaceae) | Cyprus | ON680684 | ON705769 | NA | ON863790 | ON695856 |
| Seimatosporium cyprium | L112 | Vitis vinifera (Vitaceae) | Cyprus | ON695889 | ON692404 | NA | ON863791 | ON695848 |
| Seimatosporium discosioides | NBRC 10420 | Punica granatum (Lythraceae) | Japan | AB594800 | AB593732 | NA | NA | LC047771 |
| Seimatosporium germanicum | CBS 437.87 * | NA | Germany | MH554047 | MH554259 | MH554957 | MH554482 | MH554723 |
| Seimatosporium gracile | CFCC 55167 * | Rosa xanthina (Rosaceae) | China | OK560638 | OK560408 | ON055456 | OM986927 | OM301650 |
| Seimatosporium grevilleae | ICMP 10981 | Protea sp. (Proteaceae) | South Africa | AF405304 | AF382372 | NA | NA | NA |
| Seimatosporium luteosporum | CBS 142599 * | Vitis vinifera (Vitaceae) | USA | KY706284 | KY706309 | NA | KY706334 | KY706259 |
| Seimatosporium marivanicum | CBS 143781 * | Vitis vinifera (Vitaceae) | Iran | MW361952 | MW361960 | NA | MW375358 | MW375352 |
| Seimatosporium marivanicum | CBS 143780 | Vitis vinifera (Vitaceae) | Iran | MW361951 | MW361959 | NA | MW375357 | MW375351 |
| Seimatosporium nonappendiculatum | CFCC 55168 * | Rosa laevigata (Rosaceae) | China | OK560657 | OK560427 | ON055475 | OM986946 | OM301669 |
| Seimatosporium parvum | CFCC 55164 * | Rosa spinosissima (Rosaceae) | China | OK560647 | OK560417 | ON055465 | OM986936 | OM301659 |
| Seimatosporium parvum | CFCC 55165 | Rosa helenae (Rosaceae) | China | OK560653 | OK560423 | ON055471 | OM986942 | OM301665 |
| Seimatosporium physocarpi | CBS 139968 * | Physocarpus opulifolius (Rosaceae) | Russia | KT198722 | KT198723 | MH554917 | MH554434 | MH554676 |
| Seimatosporium physocarpi | CBS 789.68 | Physocarpus amurensis (Rosaceae) | Netherlands | MH554066 | MH554278 | MH554979 | MH554502 | MH554742 |
| Seimatosporium pistaciae | CPC 24455 * | Pistacia vera (Anacardiaceae) | Iran | KP004463 | KP004491 | MH554915 | MH554432 | MH554674 |
| Seimatosporium pistaciae | CPC 24457 |
Pistacia vera
(Anacardiaceae) | Iran | MH554126 | MH554331 | MH555035 | MH554561 | MH554799 |
| Seimatosporium pseudorosae | MFLU 14-0468 * | Rosa villosa (Rosaceae) | Italy | NA | KU359035 | NA | NA | NA |
| Seimatosporium restionis | CBS 118154 * |
Restio filiformis
(Restionaceae) |
South
Africa | DQ278922 | DQ278924 | NA | NA | NA |
| Seimatosporium rosae | CBS 139823 * | Rosa kalmiussica (Rosaceae) | Russia | KT198726 | KT198727 | LT853153 | LT853203 | LT853253 |
| Seimatosporium soli | CBS 941.69 * | Forest soil | Denmark | MH554071 | MH554282 | MH554983 | MH554507 | NA |
| Seimatosporium tibetense | CGMCC 3.23503 * | NA | China | OR247936 | OR247954 | OR380975 | OR361511 | OR381084 |
| Seimatosporium tibetense | LC15857 | NA | China | OR247937 | OR247955 | OR380976 | OR361512 | OR381085 |
| Seimatosporium tostum | NBRC 32626 | NA | Unknown | AB594795 | AB593727 | NA | NA | NA |
| Seimatosporium vaccinii | ICMP 7003 |
Vaccinium ashei
(Ericaceae) | New Zealand | NA | AF382374 | NA | NA | NA |
| Seimatosporium vitifusiforme | CBS 142600 * | Vitis vinifera (Vitaceae) | USA | KY706296 | KY706321 | NA | KY706346 | KY706271 |
| Seimatosporium vitis | MFLUCC 14-0051 * | Vitis vinifera (Vitaceae) | Italy | KR920363 | KR920362 | NA | NA | NA |
| Seimatosporium vitis-viniferae | CBS 123004 * | Vitis vinifera (Vitaceae) | Spain | MH553992 | MH554211 | MH554901 | MH554418 | MH554660 |
| Seimatosporium vitis-viniferae | CBS 116499 | Vitis vinifera (Vitaceae) | Iran | MH553984 | MH554201 | MH554884 | MH554402 | MH554643 |
Disclaimer/Publisher’s Note: The statements, opinions and data contained in all publications are solely those of the individual author(s) and contributor(s) and not of MDPI and/or the editor(s). MDPI and/or the editor(s) disclaim responsibility for any injury to people or property resulting from any ideas, methods, instructions or products referred to in the content. |
© 2024 by the authors. Licensee MDPI, Basel, Switzerland. This article is an open access article distributed under the terms and conditions of the Creative Commons Attribution (CC BY) license (https://creativecommons.org/licenses/by/4.0/).
Share and Cite
Yang, H.; Cheng, J.; Dili, N.; Jiang, N.; Ma, R. Seimatosporium chinense, a Novel Pestalotioid Fungus Associated with Yellow Rose Branch Canker Disease. Pathogens 2024, 13, 1090. https://doi.org/10.3390/pathogens13121090
Yang H, Cheng J, Dili N, Jiang N, Ma R. Seimatosporium chinense, a Novel Pestalotioid Fungus Associated with Yellow Rose Branch Canker Disease. Pathogens. 2024; 13(12):1090. https://doi.org/10.3390/pathogens13121090
Chicago/Turabian StyleYang, Haoran, Jing Cheng, Nu Dili, Ning Jiang, and Rong Ma. 2024. "Seimatosporium chinense, a Novel Pestalotioid Fungus Associated with Yellow Rose Branch Canker Disease" Pathogens 13, no. 12: 1090. https://doi.org/10.3390/pathogens13121090
APA StyleYang, H., Cheng, J., Dili, N., Jiang, N., & Ma, R. (2024). Seimatosporium chinense, a Novel Pestalotioid Fungus Associated with Yellow Rose Branch Canker Disease. Pathogens, 13(12), 1090. https://doi.org/10.3390/pathogens13121090

